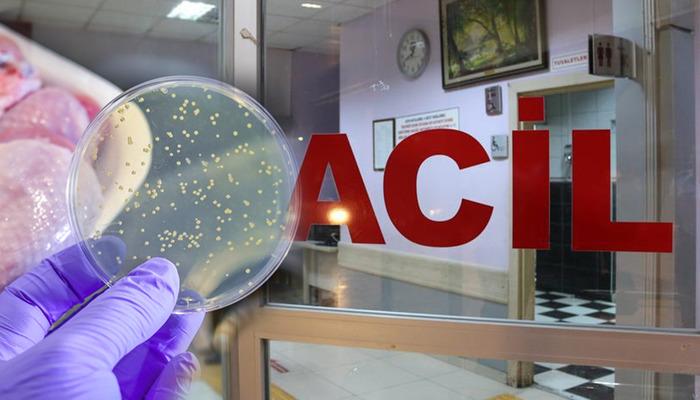

İstanbul'un Kucukcekmece Bölgesi, muhtemelen aynı aileden 4 kişi, bulantı ve baş dönmesi için pişirilen tavuğun tüketilmesinden sonra, 112 acil çağrı merkezini zehirleyerek hissederek. Aile tedavi edilirken, uzmanlar sıcaklıkta gıda zehirlenmesine karşı uyarılarını yineledi. Satış noktaları veya çeşitli sektörlerde ısı veya uygunsuz şekillerde, pişmiş gıdalar zehirlenme uzmanlarına yol açabilir, besinlerin depolanması ve tüketiminin büyük önem taşıdığını söyledi.
Şişli Hamidiye Etfal Eğitim ve Araştırma Hastanesi Acil Tıp Bölümü. Dr. Nazmiye Özcan ve Bağcalar Eğitim ve Araştırma Hastanesi Acil Tıp Exp. Mehmet Oktay Alkan ve Uzm. Dr. Süleyye Karabul önsöz bilgileri verdi.
Gıda zehirlenmesi nedir?
Ham ürünler veya uygunsuz koşullar, açık süt ve süt ürünleri gibi exp balıkları -aşırı tüketim “dedi.

“Düğün yiyecekleri gittikçe daha fazla sunulmamalı”
Uzm, “Yaz aylarında insanlar daha fazla açık yiyecek tüketiyorlar çünkü daha fazla çıkıyorlar.” Dedi. Dr. Alkan, “Bunlarda, risk riski yüksek olduğu için vakaların sayısının arttığını gözlemliyoruz. Yaz aylarında, son yıllarda tavuk tüketiminin toplum içinde arttığını gözlemliyoruz, toksik ishal hastalara hastalara çok önemli olan hastalara çok önemli olan hastalara çok önemli olan hastalara çok önemli olan hastalar için çok önemli olan hastalar için çok önemli olan hastalar için çok önemli olan hastalar için çok önemli olan hastalara çok önemli.

“Bulantı, kusma şikayetleri çok fazla şikayettir”
Gıdalarda koruma koşullarının çok önemli olduğunu vurgulayın. Dr. Nazmiye Özcan, “Acil servis bulantısı tükettiğinizde tavuk yemeği tükettiğinizde soğuk zincir kırılır, depolama koşullarına dikkat etmek için çok fazla uygulama ile şikayetleri kusar.

Özellikle bir piknik yolunda dikkat edin!
Süleyye Karabul Uzman Uzmanı, “Genellikle hastalarımız sadece güneş ışığında, sıcaklık, karın ağrısı, bulantı, kusma ve bazen ishal şikayetlerinin etkisi.

“İshal ve sıvı bozukluğu ve ölümcül olabilir”
Uzman Dr. Karabul sözlerini aşağıdaki gibi sürdürdü:
“Dış temizlik dikkat edilmez veya bilinmeyen meyveler şikayetlerle polikliniğimize ulaşabildikten sonra kesimin nasıl yapıldığı. Karpuz, zehirli bir meyve değil, her zaman tükettiğimiz bir meyve değildir. Özellikle su şeklinde suluboya kesilmiş yeni popülasyonda, somonella ve şigeller gibi, kanser ve şigeller gibi, kanser, kanser, bireyler ile birlikte, bireyler, bireyler olarak adlandırılır.

(İHA)